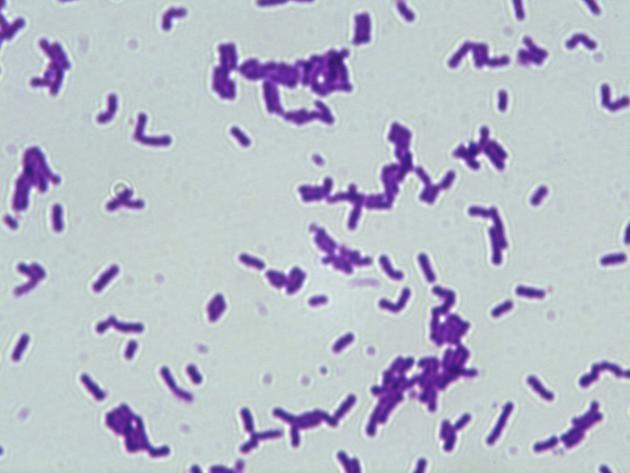

纳豆芽孢杆菌发酵制备维生素K2的多阶段调控毕业论文
2020-06-12 20:23:09
摘 要
纳豆芽孢杆菌(Bacillus subtilis natto),是现在发酵生产维生素K2的最常用的菌种,目前关于微生物发酵生产维生素K2的文献报道较多,而且目前的研究主要集中在菌种的选育和发酵工艺优化上。本课题通过多阶段转速的升速、降速以及温度的改变三种方法,利用摇瓶培养并对其pH值、甘油含量、生物量及维生素K2的含量进行考察性能研究,最后通过制备液相和高效液相色谱分析初步分析得出产物为维生素K2。通过多阶段转速和温度调控,发现当转速由150 rmp提高至250rmp,转速由250rmp降低至150rmp、静置以及温度由37℃升高至42℃下,此时的维生素K2的产量均最高。通过多阶段调控策略大大提高了纳豆芽孢杆菌发酵制备维生素K2的能力,为实现工业化生产奠定了一定的基础。本项目的实施,对于提高我国维生素K2相关产品的技术创新能力和市场竞争力以及人类战胜癌症、骨质疏松症、维生素K2缺乏性出血症等疑难疾病的折磨有着十分重要的意义。
关键词: 纳豆芽孢杆菌 维生素K2 多阶段
Multistage Regulation of Vitamin K2 Prepared by Bacillus subtilis Fermentation
Abstract
Bacillus subtilis natto is the most commonly used strain for the production of vitamin K2. At present, there are many reports on the production of vitamin K2 by microbial fermentation, and the current research mainly focuses on the breeding of bacteria and the optimization of fermentation process. In this paper, the contents of pH value, glycerol content, biomass and vitamin K2 were investigated by the method of multi-stage rotational speed, speed reduction and temperature change. Finally, And high performance liquid chromatography analysis of the preliminary analysis of the product for the vitamin K2. Through the multi-stage speed and temperature control, found that when the speed from 150 rmp to 250 rmp, speed from 250 rmp down to 150 rmp, standing and temperature from 37℃ to 42℃, when the highest yield of vitamin K2. Through the multi-stage control strategy greatly improved the ability of Bacillus subtilis fermentation preparation of vitamin K2, in order to achieve industrial production laid a foundation. The implementation of this project is of great significance to improve the technological innovation ability and market competitiveness of vitamin K2 related products in China and the torture of human diseases such as cancer, osteoporosis and vitamin K2 deficiency hemorrhage.
Key words: Bacillus natto;Vitamin K2;Multi-stage
目录
摘 要 I
Abstract 错误!未定义书签。
第一章 文献综述 1
1.1 维生素K2概述 1
1.1.1 维生素K2的简介 1
1.1.2 维生素K2的生理功能 1
1.1.3 维生素K2的应用 2
1.2 维生素K2的来源 2
1.3 多阶段调控的研究进展 3
1.4 纳豆芽孢杆菌合成VK2的代谢机理 4
1.5 本课题研究目的及意义 5
第二章 实验材料与方法 6
2.1 实验材料 6
2.1.1 实验仪器 6
2.1.2 实验试剂 7
2.2 实验方法 7
2.2.1 实验菌种 7
2.2.2 培养基的制备 7
2.2.3 培养方法 8
2.2.3 多阶段转速调控方法 8
2.2.4 多阶段温度调控方法 9
2.2.5 菌株发酵性能的检测 9
2.2.6 维生素K2提取 9
2.3 分析方法 9
2.3.1 甘油含量测定 9
2.3.2 菌体干重的测定 10
2.3.3 PH 的测定 10
2.3.4 芽孢生长情况的测定 10
2.3.5 维生素K2的检测 10
第三章 结果与讨论 11
3.1多阶段转速调控策略对菌株发酵制备VK2的影响 11
3.1.1 多阶段转速升速调控方法 11
3.1.2 多阶段转速降速调控方法 11
3.1.3 芽孢生长情况 12
3.2 多阶段温度调控方法对菌株发酵制备VK2的影响 13
3.2.1 多阶段温度调控方法 13
3.2.2 芽孢生长情况 14
3.3 VK2分离提纯的检测 14
第四章 结论与展望 16
4.1 结论 16
4.2 展望 16
参考文献 17
致 谢 19
第一章 文献综述
1.1 维生素K2概述
1.1.1 维生素K2的简介
维生素K2(Menaquinone,MK)是一种人体最主要的脂溶性维生素之一。普通食品和水果几乎不存有它,需从 6250 kg 的猪肉或 7140 kg 的鸡蛋中才可以提取 1 g的维生素 K2,因此在整个行业界中享有“铂金维生素”之称。维生素K2能够用来防止肝硬化转变为肝癌;也可以医治维生素K2不足导致的出血症,促进凝血酶原的形成,加快血液凝固,使凝血时间能够正常的维持。并且维生素K2有各种不同的结构式,一般有合成的MK-4和天然形成的MK-7,对于预防人体血管的硬化[1-2]起着首要的作用。

相关图片展示: